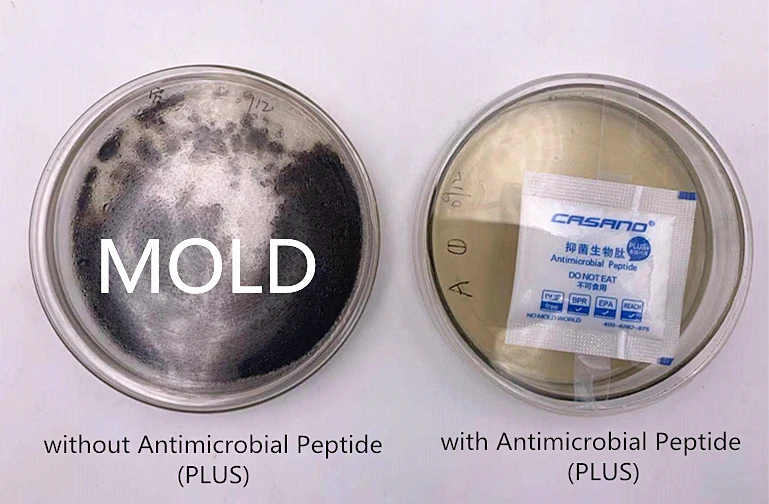

Share on (1600310845091):
Product name: | Antimicrobial Peptide Plus (Anti-mold packet) |
Size: | 5cm *5cm |
Packing: | 1000packet/bag, 10bags/carton |
Suggest usage: | 1-2 piece for product packaging, it will adjust usage quantity for product material and packaging size. |
Main material: | LDPE & Double sides adhesive tape |
Test report | REACH, DMF free, EU standard. |

New products from manufacturers at wholesale prices